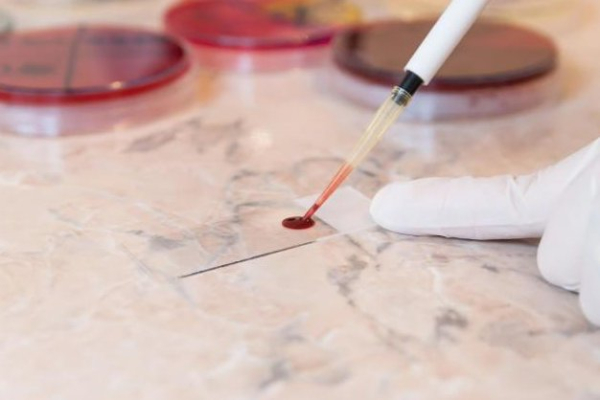
Blood testing could spot cancer early, study says

Blood testing could spot cancer early, study says

If conducted every year or every other year, the multi-cancer early detection blood test could help more people survive cancer, researchers reported Thursday in BMJ Open. Adobe stock/HealthDay
Blood tests could catch as many as half of cancers at an earlier, more treatable stage, a new study says.
If conducted every year or every other year, the multi-cancer early detection blood test could help more people survive cancer, researchers reported Thursday in BMJ Open.
“Both annual and biennial MCED screening intervals have the potential to avert deaths associated with late-stage cancers when used in addition to current guideline-based cancer screening,” concluded a research team led by Peter Sasieni, a professor of cancer epidemiology with Queen Mary University of London.
The blood test looks for many different cancer-specific signals, including DNA fragments shed by tumors, researchers said.
Only a few screenings today can reliably detect cancer among those at high risk, including tests for breast, colon, cervical and lung cancers, researchers said.
Blood testing offers an opportunity to detect dozens of different cancer types by looking for cancer markers in people’s bloodstream.
To estimate the usefulness of blood testing in regular cancer screening, researchers analyzed data from an earlier clinical trial that used the blood test to help diagnose cancer.
The analysis showed that blood testing improved early diagnosis for a wide variety of cancers.
Compared with standard cancer screening, annual blood testing was associated with 49% fewer late-stage cancer diagnoses and 21% fewer deaths within five years, results show.
Blood testing every other year resulted in 39% fewer late-stage diagnoses and 17% fewer deaths within five years, researchers added.
Among people diagnosed with an aggressive, fast-growing cancer, blood tests could avert 14% to 21% deaths within five years, results show.
“Based on the performance characteristics from a case control study, both annual and biennial screening with an MCED test have the potential to intercept 31% to 49% of cancers at stage 1-2 that would otherwise present at stage 3-4,” researchers estimate.
“Of these, approximately equal numbers would be detected at stage 1 and at stage 2,” they added.
These estimates assume complete compliance with screening schedules and follow-up testing, which is optimistic, researchers noted. They also assume that more early-stage diagnoses will automatically reduce death rates.
“The optimal choice of screening interval will depend on assessments of real-world cancer survival and the costs of confirmatory testing after MCED screening,” researchers said.
The Cleveland Clinic has more on blood tests for cancer.
